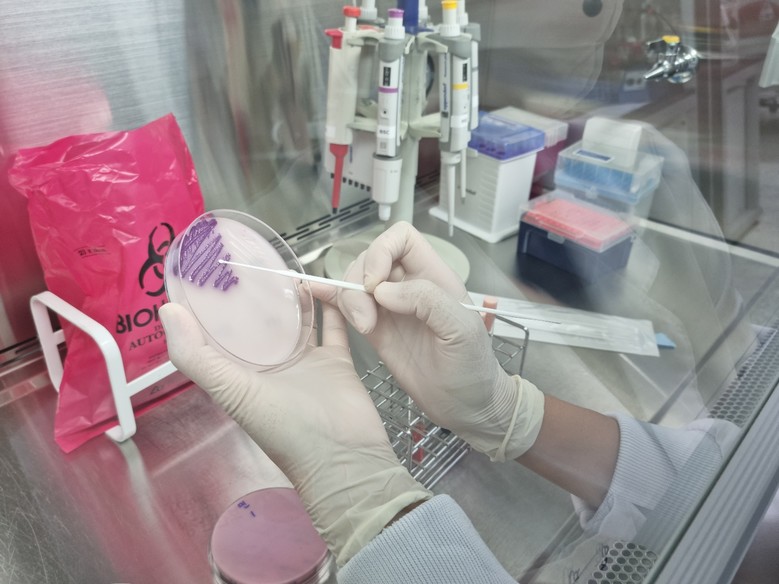

- 식당 등 음식물 관리 철저…손씻기 등 위생수칙 준수

[광주 세계타임즈=손권일 기자] 광주광역시보건환경연구원은 17일 무더위가 기승을 부리면서 세균성 장염, 수족구병 등 여름철 감염성질환이 증가함에 따라 개인 위생과 음식물 관리에 각별히 주의해줄 것을 당부했다.
광주보건환경연구원은 질병관리청 주관으로 매주 표본감시 의료기관에서 수집한 장관감염증, 수족구병 등 엔테로바이러스감염증 의심환자 검체로부터 원인병원체를 분석하는 감시사업을 수행하고 있다.
장관감염증 원인병원체 분석 결과, 세균성병원체 검출률은 ▲6월 35.1%(208건 중 73건) ▲7월 37.0%(192건 중 71건) ▲8월 첫째 주 47.9%(48건 중 23건)로 증가했으며, 이중 96%(22건)가 장병원성대장균과 살모넬라균으로 나타났다.
수족구병 검출률도 87.9%이던 5월 이후 주춤하다 7월 중순부터 다시 증가세를 보여 8월 첫째 주 검출률이 100%(11건 중 11건)로 확인되는 등 폭염 속 다양한 감염성질환이 증가하고 있다.
장병원성대장균은 오염된 육류나 채소, 살모넬라균은 계란·우유·육류 및 가공품이 주요 감염원이다. 이들 식품의 보관, 손질, 조리때 세심한 주의가 필요하다.
수족구병은 엔테로바이러스 감염에 의한 질병으로 손과 발, 입안에 물집이 잡히며 고열과 인후통이 대표 증상이다. 환자의 대변 또는 분비물(수포, 진물 등)과 접촉하거나 오염된 장난감 등을 만질 경우 쉽게 감염된다.
여름철에는 온도가 높고 습기가 많아 세균 증식이 빠르게 일어나 음식물이나 조리환경 위생에 소홀할 경우 장염에 걸리기 쉽다. 또 실내 수영장이나 계곡 등 물놀이 활동이 많아지면서 엔테로바이러스에 오염된 물이나 환자와 접촉 등을 통해 수족구병에 감염될 수 있다.
강경리 광주보건환경연구원 수인성질환과장은 “무더위가 지속되면서 장염, 수족구병뿐만 아니라 눈병이나 식중독 등 다양한 감염성질환의 발생 위험이 높아지고 있다”며 “손씻기 등 개인위생과 음식물 관리를 철저히 해야 한다”고 말했다.
[저작권자ⓒ 경북세계타임즈. 무단전재-재배포 금지]












































